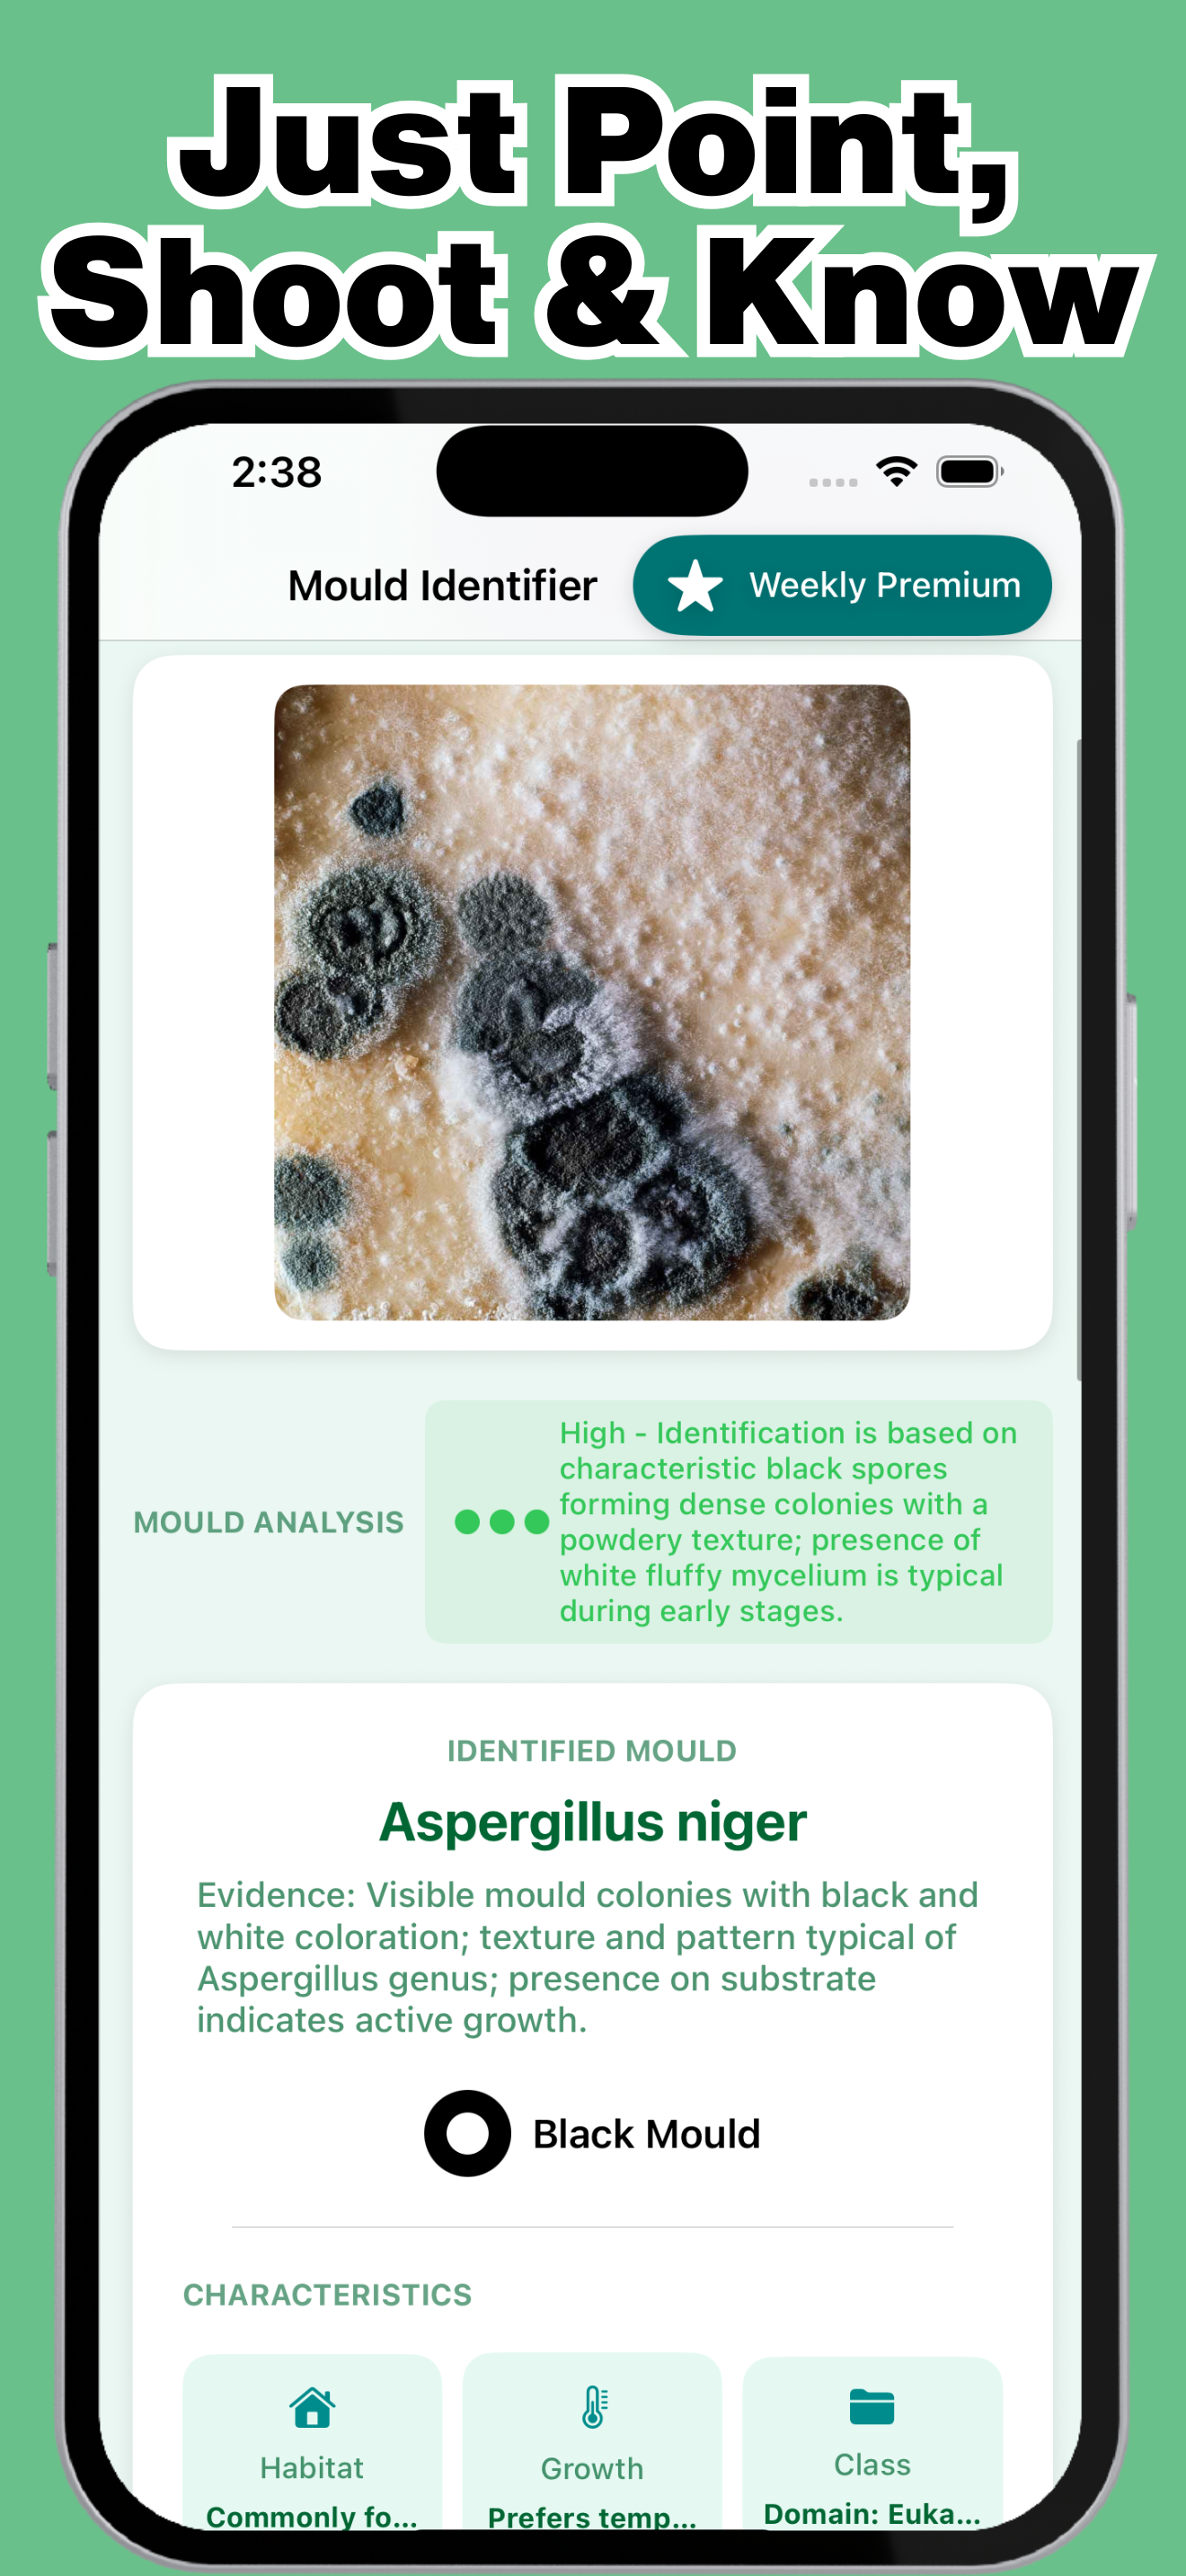
https://is1-ssl.mzstatic.com/image/thumb/PurpleSource211/v4/2a/82/7c/2a827c5f-1852-71dc-27a6-d2ffbdb8598c/4.png/1320x2868.png

Ratings & Reviews performance provides an overview of what users think of your app. Here are the key metrics to help you identify how your app is rated by users and how successful is your review management strategy.
Mould identifier - With AI Scanner Scan. Identify. Stay Safe from Toxic Mold. Worried about black mold or toxic mold in your home? Discover instant peace of mind with Mould Identifier – the #1 AI-powered mold scanner that detects dangerous mold in seconds! Simply snap a photo, and our advanced mold detection technology identifies species, assesses health risks, and provides expert safety guidance. Say goodbye to expensive mold inspections and hello to confidence. Instant Mold Detection Snap or upload photos for immediate AI mold analysis Identify black mold, green mold, and 300+ species instantly Get confidence scores and danger level ratings in seconds Perfect home mold test alternative – no lab fees required Comprehensive Health & Safety Analysis Detailed health risk assessments for every mold type Professional danger level ratings (Safe to Extremely Dangerous) Expert mold removal guidelines tailored to your situation Prevention strategies to stop mold growth permanently Track & Monitor Over Time Built-in scan history log for documentation Perfect for mold inspection records for landlords Monitor mold growth trends and remediation progress Export reports for insurance or property claims Professional-Grade Accuracy Trained on 2.5M+ mold and safety images Identifies common household to dangerous toxic mold Used by homeowners, property managers, and inspectors AI mold detection technology you can trust Why Choose Mould Identifier? Fast & Accurate: Instant mold identification with AI precision Health-Focused: Comprehensive safety assessments for protection Cost-Effective: Save thousands on professional mold inspections Easy to Use: Simple mold scanner anyone can operate Peace of Mind: Know exactly what you're dealing with Perfect For: Homeowners checking suspicious black mold spots Renters documenting mold issues for landlords Property managers conducting safety inspections Real estate agents verifying property conditions Health-conscious families protecting loved ones DIY enthusiasts tackling mold removal safely What Users Say: mold detector found hidden toxic mold behind wallpaper. Lifesaver during renovation – Jennifer L. Better than expensive mold test kits. The AI mold scanner is incredibly accurate – Michael Jones. Premium Features: Unlock unlimited mold scans, advanced rare species identification, complete 300+ mold database, detailed PDF inspection reports, and mold removal guides. Subscription Options: Weekly Premium: $4.99/week (3-day free trial, cancel anytime) Lifetime Premium: $29.99 one-time (best value, no recurring charges) Auto-renews unless cancelled 24+ hours before period ends. Manage via Apple ID Settings. Safety Notice Important Safety Information While our AI mold detector provides professional-grade mold identification, it's designed for initial assessment and educational purposes. For extensive mold contamination, structural damage, or health symptoms related to mold exposure, always consult certified mold inspection professionals for comprehensive testing, mold remediation, and removal services. Download Mould Identifier today – your essential black mold detector for a safer, healthier home Terms: https://www.becomechad.com/terms&conditions Privacy: https://www.becomechad.com/main-privacy-policy